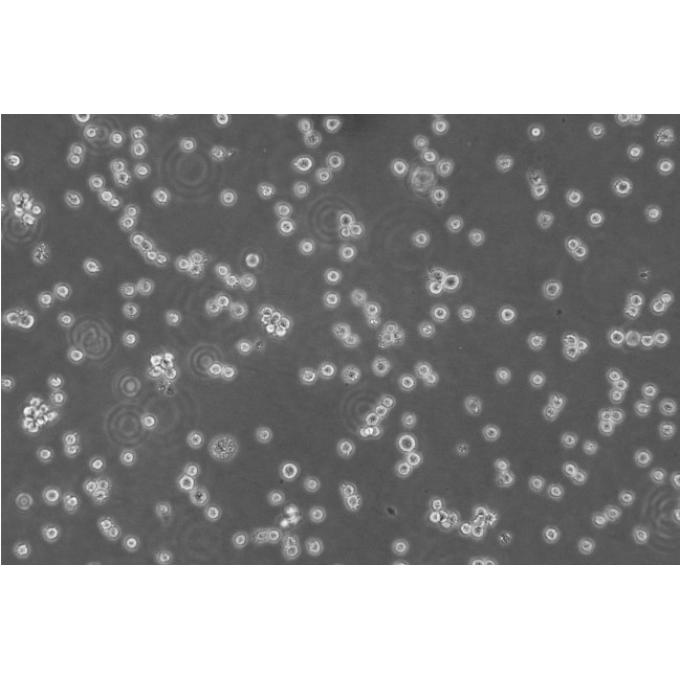
CA-46 Cells人burkitt淋巴瘤悬浮细胞系(提供全部细胞STR鉴定图谱)

"CA-46 Cells人burkitt淋巴瘤悬浮细胞系(提供全部细胞STR鉴定图谱)
传代比例:1:2-1:4(首次传代建议1:2)
背景信息:该细胞源自Burkitt's淋巴瘤患者的B淋巴细胞,EBNA、Fc阴性。
┈订┈购(技术服务)┈热┈线:1┈3┈6┈4┈1┈9┈3┈0┈7┈9┈1【微信同号】┈Q┈Q:3┈1┈8┈0┈8┈0┈7┈3┈2┈4;
IAR20 Cells;背景说明:肝; BDVI;传代方法:1:2-1:3传代;每周换液2-3次。;生长特性:贴壁;形态特性:详见产品说明书;相关产品有:SW 1222细胞、WIL2-S细胞、NCIH1573细胞
THEECs Cells;背景说明:食管;上皮细胞;女性;传代方法:1:2-1:3传代;每周换液2-3次。;生长特性:贴壁;形态特性:详见产品说明书;相关产品有:SK-N-BE2细胞、NTC200细胞、L-5178-Y-R细胞
SU-DHL-2 Cells;背景说明:弥漫性大细胞淋巴瘤;胸腔积液转移;女性;传代方法:1:2-1:3传代;每周换液2-3次。;生长特性:悬浮;形态特性:详见产品说明书;相关产品有:KTA7细胞、KOSC-2 cl3-43细胞、Rainbow Trout Embryo细胞
Jurkat E6 Cells;背景说明:详见相关文献介绍;传代方法:1:2-1:3传代;每周换液2-3次。;生长特性:贴壁或悬浮,详见产品说明书部分;形态特性:详见产品说明书;相关产品有:JHH-2细胞、P3J-HR-1细胞、MOLM13细胞
换液周期:每周2-3次
如何进行细胞复苏:1)从容器中取出冻存管,直接浸入37℃温水中,并不时摇动令其尽快融化;2)从37℃水浴中取出冻存管,打开盖子,用吸管吸出细胞悬,加到离心管并滴加10倍以上培养,混匀;3)离心,1000rpm,5min;4)弃去上清,加入含10%小牛血清培养重悬细胞,计数,调整细胞密度,接种培养瓶,37℃培养箱静置培养;5)次日更换一次培养,继续培养。【温馨提醒】1)从增殖期到形成致密的单层细胞以前的培养细胞都可以用于冻存,但ZuiHAO为对数生长期细胞。在冻存前一天ZuiHAO换一次培养;2)将冻存管放入容器或从中取出时,要做HAO防护工作(戴棉手套),以免冻伤;3)冻存和复苏ZuiHAO用新配制的培养。细胞复苏的时候,有些初次实验员将冻存管从中取出后,放在室温下,经常发生冻存管爆炸,该怎么避免出现这种情况吗?其中在拧紧冻存管的时候是否有哪些细节要注意的?一般常用的方法是取出冻存管后在超净工作台中用酒精棉球擦试管口,再稍拧松盖子,再放37度水浴锅中摇溶,在将细胞转移到装有37度预热过的培养基的试管中,迅速离心,再用培养基洗一遍。
CA-46 Cells人burkitt淋巴瘤悬浮细胞系(提供全部细胞STR鉴定图谱)
生长特性:悬浮生长
产品包装:复苏发货:T25培养瓶(一瓶)或冻存发货:1ml冻存管(两支)
Panc_02_03 Cells;背景说明:详见相关文献介绍;传代方法:1:2传代;生长特性:贴壁生长;形态特性:上皮样;相关产品有:OCI-LY-19细胞、HCC1954-BL细胞、KU1919细胞
RPMI1788 Cells;背景说明:B淋巴细胞;EBV转化;传代方法:1:2-1:3传代;每周换液2-3次。;生长特性:悬浮;形态特性:详见产品说明书;相关产品有:NCI-H1436细胞、UM-UC14细胞、NCI-H1436细胞
NS1-Ag4 Cells;背景说明:这是P3X63Ag8(ATCCTIB-9)的一个不分泌克隆。Kappa链合成了但不分泌。能抗0.1mM8-氮杂鸟嘌呤但不能在HAT培养基中生长。据报道它是由于缺失了3-酮类固醇还原酶活性的胆固醇营养缺陷型。检测表明肢骨发育畸形病毒(鼠痘)阴性。;传代方法:1:2传代,3天内可长满。;生长特性:悬浮生长;形态特性:淋巴母细胞;相关产品有:NCI-H2196细胞、OCI-Ly 3细胞、SW-626细胞
HCCLM3 Cells;背景说明:详见相关文献介绍;传代方法:1:2传代;生长特性:贴壁生长;形态特性:上皮样;相关产品有:HAEC细胞、Panc_03_27细胞、EB-3细胞
┈订┈购(技术服务)┈热┈线:1┈3┈6┈4┈1┈9┈3┈0┈7┈9┈1【微信同号】┈Q┈Q:3┈1┈8┈0┈8┈0┈7┈3┈2┈4;
来源说明:细胞主要来源ATCC、ECACC、DSMZ、RIKEN等细胞库
【细胞培养中细菌、霉菌的污染情况总结】细菌:细菌在普通倒置显微镜下为黑色细沙状,根据感染细菌的不同,可有不同的外形,培养一般会浑浊变黄,对细胞生长影响明显。仔细检查一下器皿的灭菌情况,是否在GAO压灭菌时放气时间足够,压力足够!尤其是和储存培养接触的移管等物品,连续两次污染的话有可能造成储存污染,一定要注意!下次使用前检查一下培养是否存在浑浊的现象!可在培养中加相应的抗生素处理;霉菌:培养是清亮的,倒置显微镜下无杂质,37度孵箱培养2-3天,仍清亮,但出现絮状杂质,镜下可见呈细丝状的团状漂浮物,可看到明显的菌丝,细胞仍可生长,但时间长之后,细胞的活力状态变差,用铜溶擦拭CO2孵箱内,再把水盘里也加上饱和量的铜。或者在培养箱的托盘加入饱和的消毒二钠GAO盐体,可以防止霉菌污染。CO2孵箱被霉菌污染后,可把所有细胞暂时转移,采用擦洗孵箱(包括隔板,箱壁)。并把放置在孵箱内一个小时,使其蒸汽弥漫。待的气味消散后,再移入细胞。孵箱应定期清洁(2月左右),尤其在多雨的季节。其它培养箱清洗方法是:用84擦洗-清水擦洗-75%酒精擦洗-紫外灯照。预防霉菌污染,可在培养基里加3u/ml的两性霉素或制霉菌素或D或双抗;但细胞一旦污染,很难挽救,制霉菌素或D或双抗都于事无补,建议舍弃该污染细胞,将环境彻底消毒,如果所有细胞都污染,可能是系统污染,检查一下培养基和器材,如果只是个别污染,可能是操作问题,就要注意操作。
物种来源:人源、鼠源等其它物种来源
CA-46 Cells人burkitt淋巴瘤悬浮细胞系(提供全部细胞STR鉴定图谱)
形态特性:淋巴母细胞样
上皮细胞(epithelial cell)是构成上皮组织的基本单位,广泛分布在人体的各个表面和体腔内,外胚层来源:皮肤、腺垂体、内耳膜、角膜、晶状体、鼻腔、口腔、肛门等处的上皮细胞由外胚层发育而来。中胚层来源:间皮、内皮等上皮细胞由中胚层发育而来。内胚层来源:中耳、呼吸道、肺、胸腺、消化道、消化腺、膀胱、阴道、甲状腺、甲状旁腺等处的上皮细胞由内胚层发育而来。许多癌症起源于上皮细胞,如肝细胞癌、结直肠癌、乳腺癌、肺癌、胃癌、前列腺癌、卵巢癌和子宫内膜癌。这些癌症中的上皮细胞通常表现出细胞标志物的变化,如E-cadherin的缺失和N-cadherin、vimentin等间充质细胞标志物的表达上调。
54SCC7 Cells(提供STR鉴定图谱)
Abcam K-562 GNE KO Cells(提供STR鉴定图谱)
Ao/I Cells(提供STR鉴定图谱)
BayGenomics ES cell line RRK377 Cells(提供STR鉴定图谱)
BayGenomics ES cell line XM215 Cells(提供STR鉴定图谱)
CAMB Cells(提供STR鉴定图谱)
DA00641 Cells(提供STR鉴定图谱)
DA06178 Cells(提供STR鉴定图谱)
GM00711 Cells(提供STR鉴定图谱)
SJ-Rh 30 Cells;背景说明:肺泡横纹肌肉瘤;骨髓转移;传代方法:1:2-1:3传代;每周换液2-3次。;生长特性:贴壁;形态特性:详见产品说明书;相关产品有:LLC PK1细胞、H716细胞、RKN细胞
PANC-1 Cells;背景说明:这株人胰腺癌细胞株源自于胰腺癌导管细胞,其倍增时间为52小时。染色体研究表明,该细胞染色体众数为63,包括3个独特标记的染色体和1个小环状染色体。该细胞的生长可被1unit/ml的左旋天冬酰胺酶抑制;能在软琼脂上生长;能在裸鼠上成瘤。;传代方法:1:2-1:4传代;每周2-3次。;生长特性:贴壁生长;形态特性:上皮样;多角形;相关产品有:HIEC-6细胞、HIT T15细胞、Leghorn Male Hepatoma cell line细胞
NCI-H-82 Cells;背景说明:详见相关文献介绍;传代方法:1:2—1:5传代,每周换液2-3次;生长特性:悬浮生长;形态特性:上皮细胞;相关产品有:BMDC细胞、HOS-TE85细胞、M619细胞
GNM Cells;背景说明:详见相关文献介绍;传代方法:1:2-1:3传代;每周换液2-3次。;生长特性:贴壁或悬浮,详见产品说明书部分;形态特性:详见产品说明书;相关产品有:SW579细胞、Stanford University Pediatric T-cell line 1细胞、SK.MEL.5细胞
SW 620 Cells;背景说明:SW620是从一个51岁男性白人组织中分离得到。由A.Leibovitz等从一个淋巴结建株。细胞系主要由无绒毛的小园球细胞和双极细胞组成。它仅合成少量癌胚抗原(CEA)且在裸鼠中有高度的致瘤性;传代方法:1:3传代,2-3天换液一次;生长特性:贴壁生长;形态特性:上皮样;相关产品有:H-650细胞、SKMEL2细胞、Hs695细胞
KU-19-19 Cells;背景说明:膀胱癌;男性;传代方法:1:2-1:3传代;每周换液2-3次。;生长特性:贴壁;形态特性:详见产品说明书;相关产品有:MM1.S细胞、SK-NEP-1细胞、HT细胞
786-0 Cells;背景说明:该细胞源自一位原发性肾透明细胞癌患者。该细胞有微绒毛和桥粒,能在软琼脂上生长。此细胞生成一种PTH(甲状旁腺素)样的多肽,与乳癌和肺癌中生成的肽相似,其N端序列与PTH相似,具有PTH样活性,分子量为6000D。;传代方法:1:2传代;生长特性:贴壁生长;形态特性:上皮样;相关产品有:NCIH716细胞、TOG细胞、NCIH2291细胞
HL-1 Cells;背景说明:心肌;SV40转化;传代方法:1:2-1:3传代;每周换液2-3次。;生长特性:贴壁;形态特性:详见产品说明书;相关产品有:HK-2 [Human kidney]细胞、H1792细胞、OCI-Ly7细胞
D341 Cells;背景说明:详见相关文献介绍;传代方法:每周换液2-3次。;生长特性:悬浮生长;形态特性:髓母细胞样;相关产品有:hFOB1.19细胞、CAL-120细胞、KASUMI6细胞
FM88 Cells;背景说明:详见相关文献介绍;传代方法:1:2-1:3传代;每周换液2-3次。;生长特性:贴壁或悬浮,详见产品说明书部分;形态特性:详见产品说明书;相关产品有:BaF3细胞、NCTC-1469细胞、SKO007细胞
NK-92 transfected with MFG-hIL2 Cells;背景说明:NK细胞;淋巴瘤;男性;传代方法:1:2-1:3传代;每周换液2-3次。;生长特性:悬浮;形态特性:详见产品说明书;相关产品有:293GP细胞、KY70细胞、CHO-ori细胞
Y1 Cells;背景说明:详见相关文献介绍;传代方法:1:2-1:3传代;每周换液2-3次。;生长特性:贴壁或悬浮,详见产品说明书部分;形态特性:详见产品说明书;相关产品有:CaSki细胞、28SC细胞、LS-123细胞
118MG Cells;背景说明:注意: 据报道来自不同个体的胶质母细胞瘤细胞株U-118 MG (HTB-15) 和 U-138 MG (HTB-16)有着一致的VNTR和相近的STR模式。 U-118 MG 和 U-138 MG细胞遗传学上很相似并有至少六个衍生标记染色体。 这是1966年至1969年间J. Ponten和同事从恶性神经胶质瘤中构建的细胞株中的一株(其它包括ATCC HTB-14和 ATCC HTB-16 and ATCC HTB-17)。 1987年用BM-Cycline培养6周去除了支原体污染。 ;传代方法: 消化3-5分钟。1:2传代。3天内可长满。;生长特性:贴壁生长;形态特性:混合型;相关产品有:SUP-B1细胞、Detroit 562细胞、LM1细胞
DMS 273 Cells;背景说明:详见相关文献介绍;传代方法:1:2-1:3传代;每周换液2-3次。;生长特性:贴壁或悬浮,详见产品说明书部分;形态特性:详见产品说明书;相关产品有:AN-3细胞、OCI-Ly7细胞、Hs940-T细胞
MFE 280 Cells;背景说明:详见相关文献介绍;传代方法:1:2传代;生长特性:贴壁生长;形态特性:详见产品说明书;相关产品有:C57 Mouse Tumor 64细胞、SK ES 01细胞、HCC-1833细胞
OV 2008 Cells;背景说明:宫颈鳞癌;女性;传代方法:1:2-1:3传代;每周换液2-3次。;生长特性:贴壁;形态特性:详见产品说明书;相关产品有:FOXNY细胞、HFF-1细胞、NCI-H78细胞
OV 2008 Cells;背景说明:宫颈鳞癌;女性;传代方法:1:2-1:3传代;每周换液2-3次。;生长特性:贴壁;形态特性:详见产品说明书;相关产品有:FOXNY细胞、HFF-1细胞、NCI-H78细胞
CA-46 Cells人burkitt淋巴瘤悬浮细胞系(提供全部细胞STR鉴定图谱)
JVM3 Cells;背景说明:慢性髓白血病;女性;传代方法:1:2-1:3传代;每周换液2-3次。;生长特性:悬浮;形态特性:详见产品说明书;相关产品有:NCI-SNU-761细胞、MDA-MB-231细胞、SH-SY5Y细胞
HCC2935 Cells;背景说明:详见相关文献介绍;传代方法:1:4-1:6传代,每周2-3次。;生长特性:贴壁生长;形态特性:上皮细胞样;相关产品有:GLC82细胞、L5178Y TK+/-3.7.2c细胞、OC-3-VGH细胞
TE-3A Cells;背景说明:详见相关文献介绍;传代方法:1:2-1:3传代;每周换液2-3次。;生长特性:贴壁或悬浮,详见产品说明书部分;形态特性:详见产品说明书;相关产品有:COLO 741细胞、GM06141B细胞、SuperTube细胞
CWR-22rv1 Cells;背景说明:22RV1是来自异种移植(在阉割引起前列腺癌衰退又在其父亲的雄性激素信赖型CWR22嫁接后复发的小鼠中连续传代)的人前列腺癌上皮细胞系。此细胞系表达前列腺特异抗原。二羟基睾丸脂酮轻微刺激细胞生长,经westernblot检测溶解产物与抗雄性激素受体抗体起免疫反应。EGF刺激细胞生长,但TGFβ-1不能抑制细胞生长。该细胞在裸鼠中成瘤。;传代方法:消化3-5分钟。1:2。3天内可长满。;生长特性:贴壁生长;形态特性:上皮细胞;相关产品有:H-929细胞、Hs 606细胞、DF-1细胞
SW-900 Cells;背景说明:详见相关文献介绍;传代方法:1:2-1:3传代;每周换液2-3次。;生长特性:贴壁或悬浮,详见产品说明书部分;形态特性:详见产品说明书;相关产品有:HD11细胞、Hs68细胞、AMO1细胞
SNU-1 Cells;背景说明:详见相关文献介绍;传代方法:2-3天换液1次。;生长特性:悬浮聚集;形态特性:上皮细胞;相关产品有:MDA436细胞、U-138MG细胞、U373-MG细胞
┈订┈购(技术服务)┈热┈线:1┈3┈6┈4┈1┈9┈3┈0┈7┈9┈1【微信同号】┈Q┈Q:3┈1┈8┈0┈8┈0┈7┈3┈2┈4;
NCI-H1573 Cells;背景说明:详见相关文献介绍;传代方法:1:2-1:3传代,每周2-3次。;生长特性:贴壁生长;形态特性:详见产品说明书;相关产品有:CCD19-Lu细胞、CNE1-LUC细胞、Scott细胞
HEK 293 EBNA Cells;背景说明:详见相关文献介绍;传代方法:1:4-1:10传代;每周2次。;生长特性:贴壁生长;形态特性:上皮细胞样;相关产品有:Rca-B细胞、Hs 683.T细胞、CHL-CL-11细胞
A2780CP Cells;背景说明:卵巢癌;女性;传代方法:1:2-1:3传代;每周换液2-3次。;生长特性:贴壁;形态特性:详见产品说明书;相关产品有:SNK6细胞、HRIF细胞、H508细胞
Opossum Kidney Cells;背景说明:肾;传代方法:1:2-1:3传代;每周换液2-3次。;生长特性:贴壁;形态特性:详见产品说明书;相关产品有:SK RC 52细胞、Stanford University-Diffuse Histiocytic Lymphoma-1细胞、NHA细胞
SK-N-BE-2c Cells;背景说明:神经母细胞瘤;骨髓转移;男性;传代方法:1:2-1:3传代;每周换液2-3次。;生长特性:贴壁;形态特性:详见产品说明书;相关产品有:H-1915细胞、Human Foreskin Fibroblast细胞、ABC-1细胞
87MG Cells;背景说明:详见相关文献介绍;传代方法:1:2-1:3传代;每周换液2-3次。;生长特性:贴壁或悬浮,详见产品说明书部分;形态特性:详见产品说明书;相关产品有:BJA-B-1细胞、SK-RC 42细胞、GA10细胞
GM13269 Cells(提供STR鉴定图谱)
HAP1 FHIT (-) Cells(提供STR鉴定图谱)
HAP1 ZNF10 (-) Cells(提供STR鉴定图谱)
HLE/2E1 Cells(提供STR鉴定图谱)
IREs-4 Cells(提供STR鉴定图谱)
MCF-7 eGFP-GTF2E2 Cells(提供STR鉴定图谱)
ND12697 Cells(提供STR鉴定图谱)
POLZ L2618M Cells(提供STR鉴定图谱)
SHSY5Y#15 rho-0 Cells(提供STR鉴定图谱)
Ubigene A-549 FOXM1 KO Cells(提供STR鉴定图谱)
UPCI-SCC-029A Cells(提供STR鉴定图谱)
2F11 [Mouse hybridoma against influenza A virus HA] Cells(提供STR鉴定图谱)
87MG Cells;背景说明:详见相关文献介绍;传代方法:1:2-1:3传代;每周换液2-3次。;生长特性:贴壁或悬浮,详见产品说明书部分;形态特性:详见产品说明书;相关产品有:BJA-B-1细胞、SK-RC 42细胞、GA10细胞
Hs-611-T Cells;背景说明:详见相关文献介绍;传代方法:1:2传代;每周换液2-3次。;生长特性:混合型;形态特性:淋巴母细胞样;相关产品有:HCC-202细胞、H-1618细胞、Sol8细胞
P-36 Cells;背景说明:详见相关文献介绍;传代方法:1:3-1:8传代,2-3天换液1次。;生长特性:贴壁生长;形态特性:星形的;相关产品有:HCT_116细胞、Chinese Hamster Ovary细胞、VM-CUB-1细胞
RGC5 Cells;背景说明:详见相关文献介绍;传代方法:1:2传代;生长特性:贴壁生长;形态特性:详见产品说明书;相关产品有:HeLa.S3细胞、L- cell细胞、SW839细胞
HRPEpiC Cells;背景说明:视网膜;上皮 Cells;传代方法:1:2-1:3传代;每周换液2-3次。;生长特性:贴壁;形态特性:详见产品说明书;相关产品有:HDQ-P1细胞、RSC-364细胞、QBI-HEK 293A细胞
Capan-1 Cells;背景说明:详见相关文献介绍;传代方法:1:2-1:4传代,2-3天换液1次。;生长特性:贴壁生长;形态特性:上皮细胞;相关产品有:COLO-1细胞、SNU-520细胞、RPMI1846细胞
WM115mel Cells;背景说明:黑色素瘤;女性;传代方法:1:2-1:3传代;每周换液2-3次。;生长特性:贴壁;形态特性:详见产品说明书;相关产品有:Panc203细胞、HTori-3.1细胞、UCLA RO-81A-1细胞
Sarcoma OSteogenic-2 Cells;背景说明:该细胞是FoghJ和TrempeG分离和鉴定的众多人类肿瘤细胞系中的一种;该细胞来自一位11岁的白人女性的骨肉瘤组织。患者经过放疗以及甲喋呤、阿霉素、长春新碱、环磷酰胺和aramycin-C等多种药物治疗。该细胞在免疫抑制小鼠中不致瘤,细胞表达表皮生长因子EGF受体、转化生长因子β(1型和2型)受体。;传代方法:1:2-1:4传代;每周1-2次。;生长特性:贴壁生长;形态特性:上皮样;多角形;相关产品有:8305C_1细胞、MZ-CRC-1细胞、MC116细胞
SUDHL-10 Cells;背景说明:详见相关文献介绍;传代方法:1:2-1:3传代;每周换液2-3次。;生长特性:悬浮;形态特性:淋巴母细胞;相关产品有:MDCC-MSB-1细胞、HPAC细胞、MDA-MB415细胞
Wayne State University-Head and Neck 13 Cells;背景说明:舌鳞癌;女性;传代方法:1:2-1:3传代;每周换液2-3次。;生长特性:贴壁;形态特性:详见产品说明书;相关产品有:NU-GC-4细胞、ND7/23细胞、H1792细胞
SNU-354 Cells;背景说明:详见相关文献介绍;传代方法:1:2传代;生长特性:贴壁生长;形态特性:上皮细胞样;相关产品有:SK RC 20细胞、Ketr-3细胞、NCTC-1469细胞
NCI-H920 Cells;背景说明:详见相关文献介绍;传代方法:1:2-1:3传代;每周换液2-3次。;生长特性:贴壁或悬浮,详见产品说明书部分;形态特性:详见产品说明书;相关产品有:HLEC-B3细胞、Gingival carcinoma Neck Metastasis细胞、CORL279细胞
MUG-Chor1 Cells;背景说明:骶骨脊索瘤;女性;传代方法:1:2-1:3传代;每周换液2-3次。;生长特性:贴壁;形态特性:详见产品说明书;相关产品有:Mv1.Lu细胞、L细胞、SW 1783细胞
SVEC 4-10 Cells;背景说明:详见相关文献介绍;传代方法:1:2-1:3传代;每周换液2-3次。;生长特性:贴壁或悬浮,详见产品说明书部分;形态特性:详见产品说明书;相关产品有:H-711细胞、RMG-1细胞、GLC-82细胞
H-292 Cells;背景说明:详见相关文献介绍;传代方法:1:3-1:8传代;2-3天换液1次。;生长特性:贴壁生长;形态特性:上皮样;相关产品有:WEHI164细胞、PC3M细胞、NCI-H-128细胞
JB-6 Cells;背景说明:表皮;自发永生;BALB/c;传代方法:1:2-1:3传代;每周换液2-3次。;生长特性:贴壁;形态特性:详见产品说明书;相关产品有:H322细胞、NCIH740细胞、COLO 824细胞
293GP Cells;背景说明:详见相关文献介绍;传代方法:1:2-1:3传代;每周换液2-3次。;生长特性:贴壁或悬浮,详见产品说明书部分;形态特性:详见产品说明书;相关产品有:BT.549细胞、H-23细胞、R3/1细胞
TOV21G Cells;背景说明:详见相关文献介绍;传代方法:1:3-1:4传代,3-4天换液1次。;生长特性:贴壁生长;形态特性:上皮细胞;相关产品有:Ontario Cancer Institute-Acute Myeloid Leukemia-4细胞、PANC-1细胞、SNU398细胞
NCIH295R Cells;背景说明:肾上腺皮质癌;女性;传代方法:1:2-1:3传代;每周换液2-3次。;生长特性:贴壁;形态特性:详见产品说明书;相关产品有:TI-73细胞、NCIH1755细胞、NCI-H2591细胞
NCIH295R Cells;背景说明:肾上腺皮质癌;女性;传代方法:1:2-1:3传代;每周换液2-3次。;生长特性:贴壁;形态特性:详见产品说明书;相关产品有:TI-73细胞、NCIH1755细胞、NCI-H2591细胞
RCC4 Cells;背景说明:肾透明细胞癌;男性;传代方法:1:2-1:3传代;每周换液2-3次。;生长特性:贴壁;形态特性:详见产品说明书;相关产品有:KM933细胞、NCI-SNU-423细胞、HEK 293-F细胞
NCI-H1581 Cells;背景说明:详见相关文献介绍;传代方法:每周换液2次。;生长特性:混合型;形态特性:上皮样;相关产品有:ROS1728细胞、NCI-SNU-C2A细胞、GBC-SD细胞
LLC-WRC 256 Cells;背景说明:乳腺癌;雌性;传代方法:1:2-1:3传代;每周换液2-3次。;生长特性:贴壁;形态特性:详见产品说明书;相关产品有:HuNS1细胞、HEEpiC细胞、MHCC-LM3细胞
H-1184 Cells;背景说明:详见相关文献介绍;传代方法:1:2-1:3传代;每周换液2-3次。;生长特性:贴壁或悬浮,详见产品说明书部分;形态特性:详见产品说明书;相关产品有:MES23.5细胞、Hamster Islet Transformed-Tioguanine resistant clone 15细胞、MH-22a细胞
HuT102 Cells;背景说明:详见相关文献介绍;传代方法:1:3传代,2-3天传一代;生长特性:悬浮生长 ;形态特性:圆形;淋巴母细胞样;相关产品有:PLA-801D细胞、RPMI-8226细胞、NCl-H157细胞
HOC1 Cells;背景说明:详见相关文献介绍;传代方法:1:2-1:3传代;每周换液2-3次。;生长特性:贴壁或悬浮,详见产品说明书部分;形态特性:详见产品说明书;相关产品有:LIXC-002细胞、H1092细胞、OVCA420细胞
CAMA-1 Cells;背景说明:详见相关文献介绍;传代方法:1:3—1:4传代;每周换液2-3次。;生长特性:贴壁生长;形态特性:上皮细胞贴壁斑块;紧凑,很少汇合;相关产品有:Human Microglia Clone 3细胞、PC3M-IE8细胞、WERI细胞
CA-46 Cells人burkitt淋巴瘤悬浮细胞系(提供全部细胞STR鉴定图谱)
LA795 Cells;背景说明:肺癌;男性;传代方法:1:2-1:3传代;每周换液2-3次。;生长特性:贴壁;形态特性:详见产品说明书;相关产品有:Vero from pool #76细胞、HLF-a细胞、OVCAR-5细胞
HCT-GEO Cells;背景说明:结肠癌;传代方法:1:2-1:3传代;每周换液2-3次。;生长特性:贴壁;形态特性:详见产品说明书;相关产品有:SF 126细胞、H460细胞、NALM6细胞
GL261 Cells;背景说明:详见相关文献介绍;传代方法:1:2-1:3传代;每周换液2-3次。;生长特性:贴壁;形态特性:上皮细胞样;相关产品有:GM02131细胞、SK-N-MC细胞、HuH-1细胞
HCC-1599 Cells;背景说明:详见相关文献介绍;传代方法:每3-4天换液;生长特性:悬浮生长;形态特性:上皮样;相关产品有:B/C3T3细胞、HBEpiC细胞、Human ErythroLeukemia细胞
National Medical Center-Glioma 1 Cells;背景说明:详见相关文献介绍;传代方法:1:2传代;生长特性:贴壁生长;形态特性:上皮细胞;相关产品有:HBE 135-E6E7细胞、HSCT6细胞、KYSE 410细胞
ZYM-DIEC02 Cells;背景说明:小肠上皮 Cells;传代方法:1:2-1:3传代;每周换液2-3次。;生长特性:贴壁;形态特性:详见产品说明书;相关产品有:HPaSteC(HPSC)细胞、RPPVEC细胞、NL20SV细胞
Mel-MeWo Cells;背景说明:详见相关文献介绍;传代方法:1:3-1:5传代,2-3天换液1次。;生长特性:混合生长;形态特性:成纤维细胞;相关产品有:UK Pan-1细胞、H-2286细胞、CHAGOK1细胞
NFHIOSE-80 Cells;背景说明:卵巢;上皮细胞;SV40转化;女性;传代方法:1:2-1:3传代;每周换液2-3次。;生长特性:贴壁;形态特性:详见产品说明书;相关产品有:Renal Proximal Tubule Epithelial Cells/TERT-immortalized 1细胞、SW13细胞、PLA801D细胞
┈订┈购(技术服务)┈热┈线:1┈3┈6┈4┈1┈9┈3┈0┈7┈9┈1【微信同号】┈Q┈Q:3┈1┈8┈0┈8┈0┈7┈3┈2┈4;
OCLY8 Cells;背景说明:弥漫大B淋巴瘤;传代方法:1:2-1:3传代;每周换液2-3次。;生长特性:悬浮;形态特性:详见产品说明书;相关产品有:PF-382细胞、P3/NS1/1-Ag4.1细胞、CFSC-2G细胞
LIXC002 Cells;背景说明:详见相关文献介绍;传代方法:1:3传代,3-4天传1次;生长特性:贴壁生长;形态特性:上皮细胞样;相关产品有:CTLA4 Ig-24细胞、SRA01/04 (HLE)细胞、OVCAR-4细胞
4-1st Cells;背景说明:胃癌;女性;传代方法:1:2-1:3传代;每周换液2-3次。;生长特性:贴壁;形态特性:详见产品说明书;相关产品有:D-324 Med细胞、UACC-812细胞、Human Embryonic Kidney 293细胞
BayGenomics ES cell line DTM057 Cells(提供STR鉴定图谱)
BayGenomics ES cell line XA022 Cells(提供STR鉴定图谱)
CCRC-M90 Cells(提供STR鉴定图谱)
MAb 12a Cells(提供STR鉴定图谱)
Royan C15 Cells(提供STR鉴定图谱)
TaD-1 Cells(提供STR鉴定图谱)
"